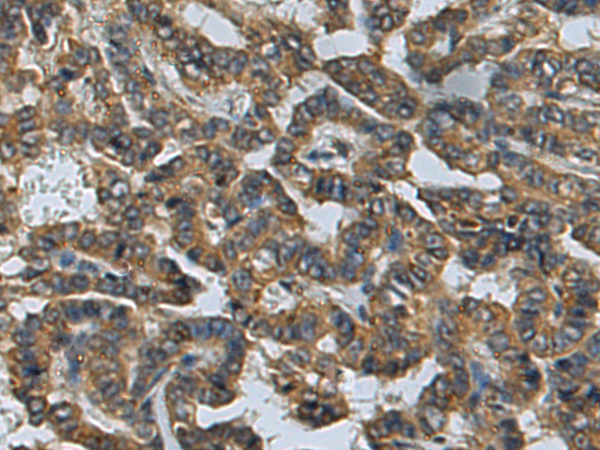
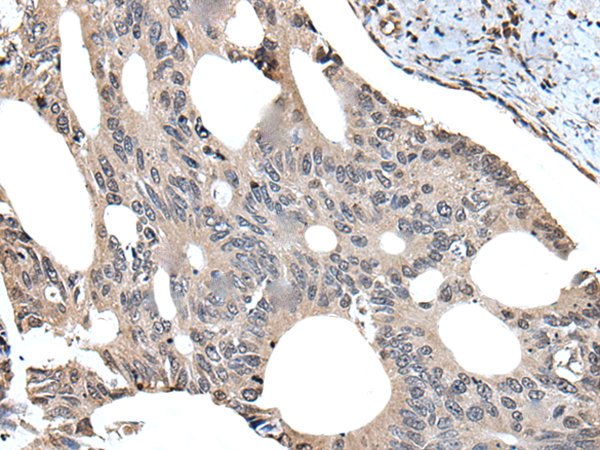
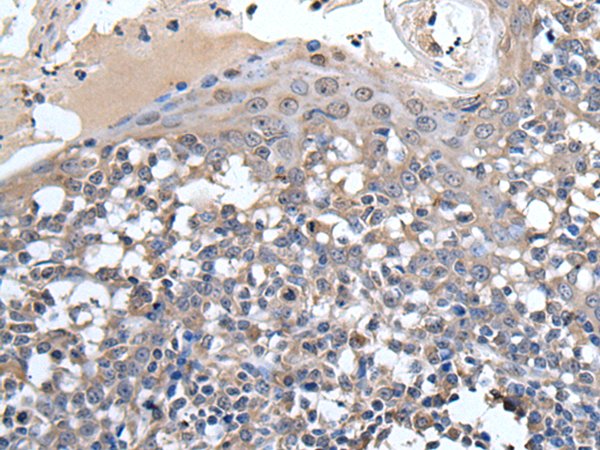

-
分类: 科研抗体货号: P09349别名: G5; BAT4; D6S54E; ANKRD59; GPATCH10应用: IHC反应种属: Human, Mouse
-
分类: 科研抗体货号: P09329别名: UBP; SIH003应用: IHC反应种属: Human, Mouse
-
分类: 科研抗体货号: P09304别名: CIR1; UEV1; CROC1; UBE2V; UEV-1; UEV1A; CROC-1应用: WB,IHC反应种属: Human, Mouse
-
分类: 科研抗体货号: P09347别名: IRTKS应用: WB,IHC反应种属: Human, Mouse, Rat
-
分类: 科研抗体货号: P09325别名: USP16; USP23应用: IHC反应种属: Human, Mouse, Rat
-
分类: 科研抗体货号: P09303别名: UBC4/5; UBCH5C; E2(17)KB3应用: WB,IHC反应种属: Human, Mouse, Rat
-
分类: 科研抗体货号: P09346别名:应用: IHC反应种属: Human, Mouse, Rat
-
分类: 科研抗体货号: P09324别名: UBH1; USP12L1应用: WB,IHC反应种属: Human, Mouse
-
分类: 科研抗体货号: P09302别名: UBC16; UBC-16应用: IHC反应种属: Human, Mouse, Rat
-
分类: 科研抗体货号: P09345别名: B4GALT; GALGT2应用: IHC反应种属: Human

鄂公网安备42018502007531号
鄂公网安备42018502007531号

